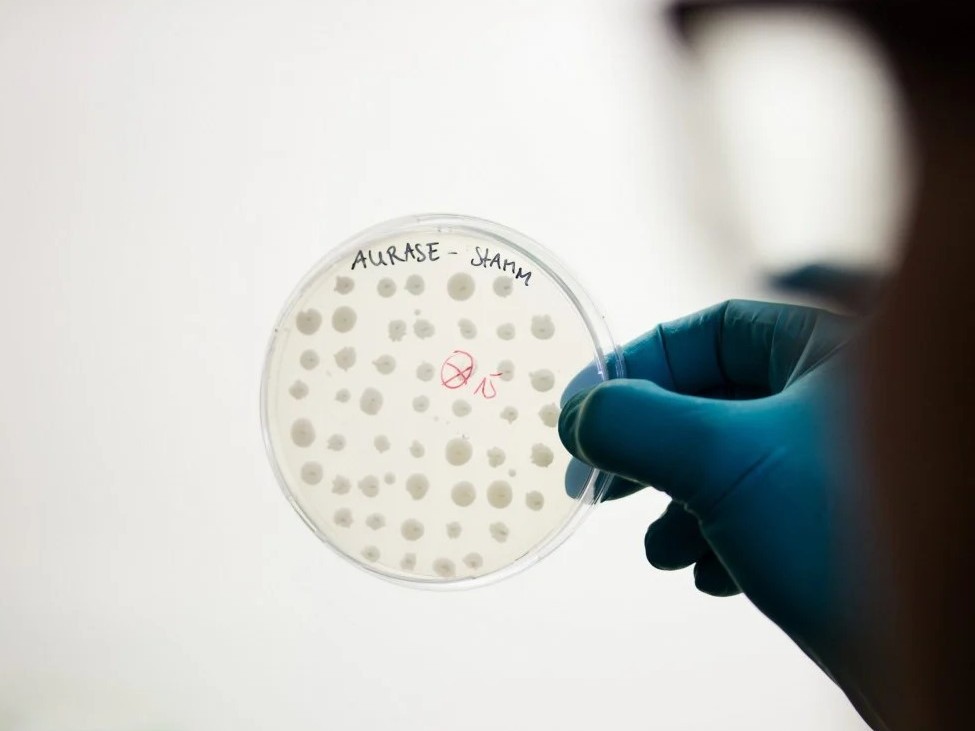
SolasCure announces Series A raise

Posted 26th September 2025
Posted 9 months ago
By GSVerdeGroup
GS Verde Group wins International Deal of the Year at Dealmakers Awards 2025
GS Verde Group, is delighted to announce that it has won the prestigious International Deal of the Year award at the Dealmakers Awards 2025, held at the Holland House Hotel in Cardiff.